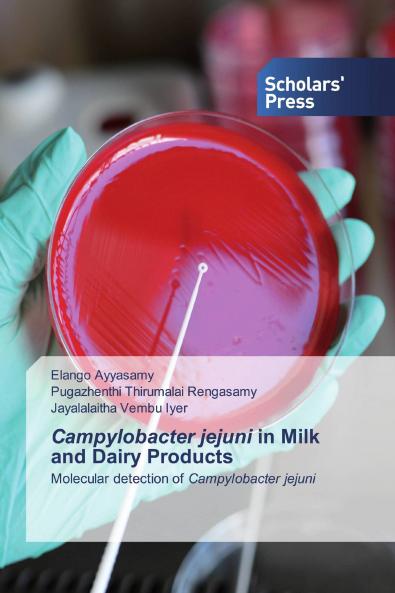
Campylobacter jejuni in Milk and Dairy Products

English
Paperback
₹7804
(All inclusive*)
Delivery Options
Please enter pincode to check delivery time.
*COD & Shipping Charges may apply on certain items.
Review final details at checkout.
Looking to place a bulk order? SUBMIT DETAILS
About The Book
Description
Author
Campylobacter jejuni a Gram-negative microaerophilic and thermotrophic spiral rod is now recognized as a leading cause of acute bacterial gastroenteritis in humans world wide and has been implicated as the causative agent of several food-associated outbreaks of disease. The bovine intestinal tract is a known reservoir of C. jejuni and is excreted through faeces and animal secretions and dairy cattle get infected through ingestion of water and feeds contaminated with manure. Humans get infected through ingestion of contaminated non-pasteurized milk improperly pasteurized milk and poultry meat. A 2017 U.S. FoodNet surveillance study reported 9421 (38.48%) cases of Campylobacter infection among 24484 bacterial foodborne infections (2018). This book deals with a study undertaken to investigate the prevalence of Campylobacter jejuni in milk and dairy products and to establish the identification and characterization of Campylobacter jejuni by rapid molecular methods like PCR PCR-RFLP and RAPD analysis and also to exploit the antagonistic potential of lactic acid bacteria and essential oils to explore the possibility of employing in mitigating Campylobacters in food systems.
Delivery Options
Please enter pincode to check delivery time.
*COD & Shipping Charges may apply on certain items.
Review final details at checkout.
Details
ISBN 13
9786138931430
Publication Date
-26-05-2020
Pages
-180
Weight
-252 grams
Dimensions
-150x220x9.85 mm